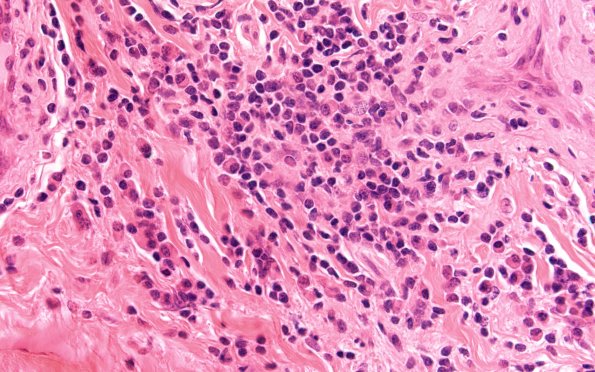
3A3 HIV, Vasculitis (Case 3) H&E 60X 1

Table of Contents
Washington University Experience | PERIPHERAL NEUROPATHY | 10 INFECTION | 2 Cytomegalovirus (in AIDS) | 3A3 HIV, Vasculitis (Case 3) H&E 60X 1
The inflammatory infiltrate is not accompanied by CMV inclusions (despite extensive searching) and CMV immunohistochemistry was, unfortunately, not performed on this old case.